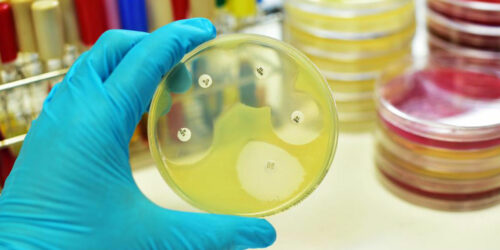
Know about the Different Types of Meningitis and Its Prevention

Different Types of Treatment for Chronic Bronchitis
Bronchitis is an acute condition in the respiratory system and over millions of people across the world suffer from it. Every year, health practitioners note an alarming increase in the number of patients who visit chronic bronchitis treatment centers. Bronchitis can be of two types, acute and chronic. Chronic bronchitis is also said to be a type of chronic obstructive pulmonary disease (COPD).
Read More